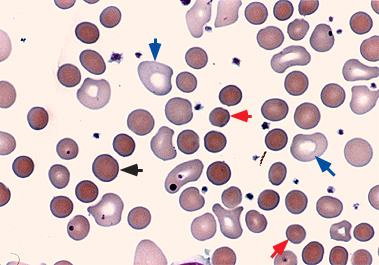
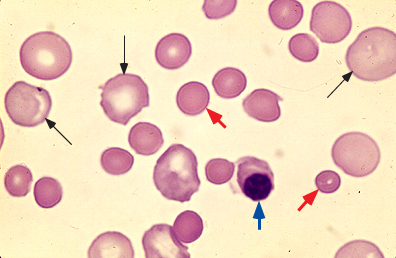

Warm autoimmune hemolytic anemia
Warm agglutinins의 존재로 인한 자가 면역 용혈성 빈혈(AIHA)은 거의 항상 body temperature에서 적혈구 (RBC) 표면의 단백질 항원과 반응하는 IgG 항체의 존재 때문입니다. 이러한 이유 때문에 그들은 적혈구를 직접 응집시키지 않더라도 "warm agglutinins"라고 불립니다.
말초혈액도말은 보통은 spherocytosis를 나타냅니다. 가장 종종 single이고 doublets은 거의 없습니다. 경한 경우에는 spherocytes가 분명하지 않을 수도 있습니다. Red blood cell (RBC) indices는 spherocytes의 존재와 reticulocytes 비율의 증가를 나타내는 MCV의 증가와 일맥상통하는 증가된 mean corpuscular hemoglobin concentration (MCHC)를 보입니다. RBCs에 결합하는 eosin-5’-maleimide (EMA)에 대한 flow cytometry-based assay는 AIHA와 hereditary spherocytosis 사이를 효과적으로 구분합니다. HS에서는 결합이 감소합니다.
Peripheral blood smear in autoimmune hemolytic anemia (AIHA)
This peripheral blood smear from a patient with AIHA due to a warm-reactive immunoglobulin G (IgG) antibody demonstrates the presence of many dark red, small microspherocytes (red arrows) and larger spherocytes (black arrow) (x1000). Many large, irregular, blue-tinted red cells are also present, representing reticulocytes (blue arrows).
Reproduced from: Ware RE. Autoimmune hemolytic anemia. In: Nathan and Oski's Hematology of Infancy and Childhood, 7th Ed, Orkin S, Nathan DG, Ginsburg D, et al (Eds), Saunders, Philadelphia 2009. Illustration used with the permission of Elsevier Inc.
Peripheral smear in severe autoimmune hemolytic anemia
Peripheral blood smear from a patient with Coombs-positive autoimmune hemolytic anemia. The smear shows the presence of many spherocytes (red arrows), one nucleated red blood cell (blue arrow), and a number of larger polychromatophilic red cells (black arrows), representing a reticulocytosis in response to the anemia.
Courtesy of Carola von Kapff, SH (ASCP).
Normal peripheral blood smear

High-power view of a normal peripheral blood smear. Several platelets (arrowheads) and a normal lymphocyte (arrow) can also be seen. The red cells are of relatively uniform size and shape. The diameter of the normal red cell should approximate that of the nucleus of the small lymphocyte; central pallor (dashed arrow) should equal one-third of its diameter.
Courtesy of Carola von Kapff, SH (ASCP).
Laboratory findings in patients with warm agglutinin AIHA include hemolytic anemia of varying severity, a reticulocytosis in response to the anemia, the presence of spherocytic red cells on the peripheral blood smear, and a positive direct antiglobulin (Coombs) test.
REF. UpToDate 2019.06.23